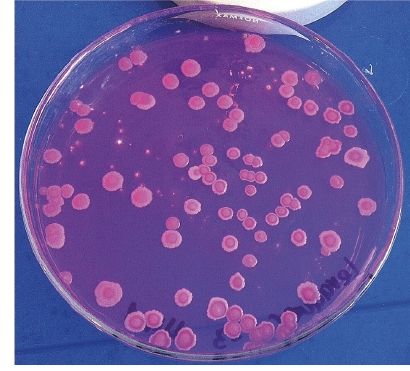
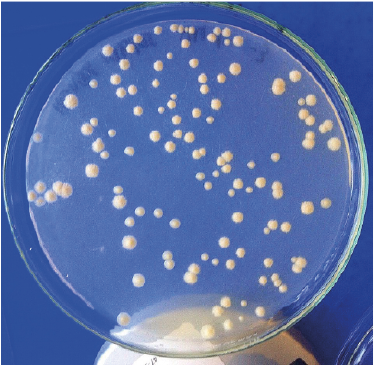

25 de agosto: Retos productivos y comerciales de la cereza en la Conferencia Digital Redagrícola Santiago
Un nutrido número de expertos brindarán este martes 25 de agosto sus conocimientos sobre nutrición foliar, uso de las cubiertas, claves en la fisiología del crecimiento del fruto y otros aspectos relacionados al comportamiento de la cereza en los mercados del mundo. Todo ello en la cuarta sesión de la Conferencia Redagricola Santiago, que se realizará desde las 10:00 am a 13:00 (Hora Chile).
Para poder matricularte, haz clic aquí.
La Conferencia Redagrícola Santiago se realiza el 18, 19, 25 y 26 de agosto de 10:00 a 13:00 (Hora Chile) / 09:00 a 12:00 (Hora Perú/Colombia). En tanto, la tercera sesión del 24 de agosto será de 15:00 a 21:00 (Hora Chile) / 14:00 a 20:00 (Hora Perú/Colombia).
Este año, nuestras conferencias se realizarán en formato online desde nuestra nueva Plataforma educacional y serán transmitidas por videoconferencia (clickmeeting). A través de la plataforma los asistentes no solo verán las charlas en tiempo real, sino que también accederán a material adicional como textos, artículos, videos, powerpoints y foros de preguntas. Todo el material quedará disponible y los participantes podrán revisar las charlas nuevamente cuando quieran.
Estas son las exposiciones programadas :
SESIÓN 4 – 25 AGOSTO: CEREZAS
- “Nutrición Foliar, qué parámetros la afectan?.Tecnología Basfoliar Premium SL. – José Gutierrez, Representante de Compo Expert
- “Últimos avances en el estudio de cubiertas en cerezos” – Dr. Richard Bastías, investigador de la Universidad de Concepción
- “Factores clave de la fisiología del crecimiento de fruto y uso de Vigofort Ultra para incrementar calibre en Cerezo” – Ing. Agr. Orlando López Salomón, Gerente Técnico de Agroenzymas Sudamérica
- “Análisis comercial y del comportamiento de la cereza chilena en los mercados” – Cristian Tagle, presidente del Comité de Cerezas de Chile
- “Comparación productiva de distintos sistemas de conducción en cerezo y análisis del sistema de conducción bajo parrón” – Marcelo Correa, asesor
- “Cadena de humedad, una herramienta efectiva para disminuir la deshidratación” – Sebastián Johnson, gerente de Proyectos Industriales Johnson, y Valentina Vasely, jefa del departamento de I+D de Proyectos Industriales Johnson
Conoce a los expertos que darán las charlas:
JOSÉ GUTIÉRREZ GONZÁLEZ
Gerente técnico en Compo Expert Chile, Perú y Colombia
José es Ing. Agrónomo de la Pontificia Universidad Católica de Chile, con estudios en la Escuela Agrícola de San Felipe. Se ha desempeñado profesionalmente en el departamento técnico de empresas exportadoras, dando asesoría y soporte técnico en campos propios como de terceros. Tiene experiencia en Seguimiento Nutricional y en Manejo de riego con sondas de capacitación. Actualmente se desempeña como, Gerente Técnico en Compo Expert, dando soporte en Chile, Perú y Colombia principalmente.
RICHARD BASTÍAS
Investigador de la Universidad de Concepción
El Dr. Bastías es profesor asociado de Fruticultura en la Facultad de Agronomía de la Universidad de Concepción. Sus líneas de investigación se enmarcan en el ámbito de la fisiología de árboles frutales, sistemas de protección climática de huertos y fruticultura de precisión. Es uno de los mayores referentes a nivel nacional e internacional en producción de cultivos frutales bajo coberturas, demostrado a través de sus publicaciones científicas y técnicas, presentaciones a Congresos y Seminarios y formación de posgraduados (magíster y doctorados), en esta temática. Es el inventor de las mallas bicolores de foto-selectividad combinada para mitigar el estrés por excesiva radiación solar y altas temperaturas en frutas; tecnología que ha sido patentada, licenciada en Chile y en el extranjero, y actualmente utilizada por productores de manzanas, uvas y berries.

ORLANDO LÓPEZ SALOMÓN
Gerente Técnico de Agroenzymas Sudamérica
Ing. Agrónomo especialista en fitotecnia egresado de la Universidad Autónoma Chapingo, con especialización en Nutrición y Fisiología Vegetal lleva más de 15 años trabajando con reguladores de crecimiento y bioestimulantes en frutales caducifolios, berries y cultivos hortícolas en agricultura protegida en México y Sudamérica. Dentro de sus logros profesionales destacan la introducción y uso de nuevas citocininas y auxinas en frutales y berries bajo agricultura protegida para lograr mayor calibre de frutos y crecimiento de raíces, también el desarrollo y lanzamiento de nuevos productos para el estrés vegetal biótico y abiótico.
CRISTIAN TAGLE
Presidente del Comité de Cerezas
Cristian posee un MBA por la Pontificia Universidad Católica de Chile. Ha jugado un papel destacado en el negocio de la cereza chilena, impulsando el negocio con el mercado chino. Además de ser presidente del Comité de Cerezas, se desempeña como gerente comercial de la Agrícola San Francisco Lo Garcés.

MARCELO CORREA DONOSO
Asesor de cerezos, kiwis y pomáceas.
Marcelo es ingeniero agrónomo de la Universidad de Chile. Trabajó durante más de una década en Exportadora Chiquita Frupac y años más tarde en Exportadora Agua Santa, siempre en el área de pomáceas. También se ha desempeñado como jefe de sucursal o asesor técnico en las empresas de agroinsumos CALS, CODIAGRO e INNOAGROK. Desde 2002 a la fecha trabaja como gerente general en Sociedad Agrícola Correa e Hijos Lda., empresa dedicada al rubro frutícola. Desde 2018 es profesor ad honorem de la Facultad de Agronomía de la Universidad de Talca, Fruticultura.

SEBASTIÁN JOHNSON
Gerente general de Proyectos Industriales Johnson
Sebastián es administrador agrícola. Forma la sociedad Comercial Johnson que, entre los años 1990 y 1999, se dedica a la producción e industrialización de hortalizas para venta a los supermercados. Entre los años 2000 a 2013 trabajó como Gerente de Producción de la Faenadora de Cerdos Agrosuper y Maxagro. Desde el año 2014, es socio y asume como Gerente General de la empresa Proyectos Industriales Johnson Ltda, dedicada a la Humidificación, Climatización y Purificación de Aire con Ozono. Es asesor de Poscosecha de uva y cereza para el rubro agrícola, así como también, diseño del concepto de Cadena de Humedad para incrementar la vida útil de la fruta.

VALENTINA VASELY
Jefa del departamento de I+D de Proyectos Industriales Johnson
Valentina es Ingeniera Agrónoma de la Universidad de Chile. Se ha desempeñado como investigadora especializada en fruticultura en el Centro de Estudios de Zonas Áridas de la Universidad de Chile y en el Centro de Evaluación Rosario. Actualmente lidera el área de investigación y desarrollo en Proyectos Industriales Johnson, centrando su investigación en la postcosecha de especies frutales, particularmente cereza y uva de mesa.
